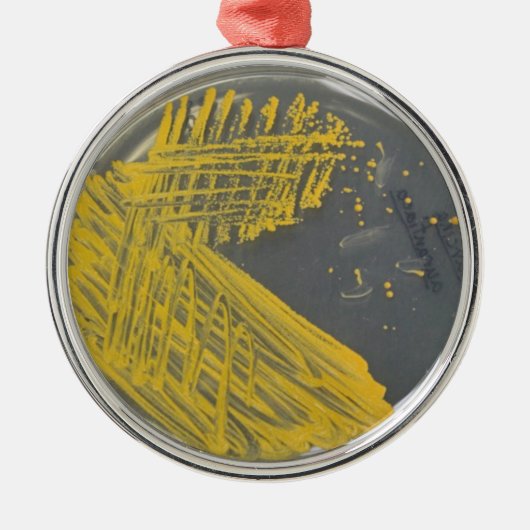
Isolierungs-Streifen der Bakterien Silbernes Ornament (Vorne)

Über Ornaments
Verkauft von
Über dieses Design
Isolierungs-Streifen der Bakterien Silbernes Ornament
Dieses ist ein Isolierungsstreifen einer allgemeinen Klimabakterie Sarcina auf einer Petrischale.
Automatische Übersetzung
Kundenrezensionen
5.0 von 5 Sternen Bewertung4 Bewertungen insgesamt
4 Bewertungen
Bewertungen für ähnliche Produkte
5 von 5 Sternen Bewertung
Von O.27. Januar 2022 • Geprüfter Kauf
Quadratisches Ornament aus Keramik
Bewertungsprogramm bei Zazzle
Sieht toll aus 😍 absolute Weiterempfehlung. Tolle Qualität, gerne wieder
5 von 5 Sternen Bewertung
Von I.29. Januar 2021 • Geprüfter Kauf
Kreis Ornament aus Keramik
Bewertungsprogramm bei Zazzle
Das Produkt hat eine sehr gute Qualität. es ist alles genau so wie erwartet!
5 von 5 Sternen Bewertung
Von A.6. Oktober 2014 • Geprüfter Kauf
Bewertungsprogramm bei Zazzle
Bei mir dreht es sich am Spiegel und es erinnert mich immer an meine schönen Urlaube auf Mahé.... Super, kratzt nicht ab, schöne Farben
Originalprodukt
Tags
Andere Informationen
Produkt ID: 175458606183141565
Gemacht am: 26.7.2016, 11:38
Bewertung: G
Zuletzt angesehene Produkte